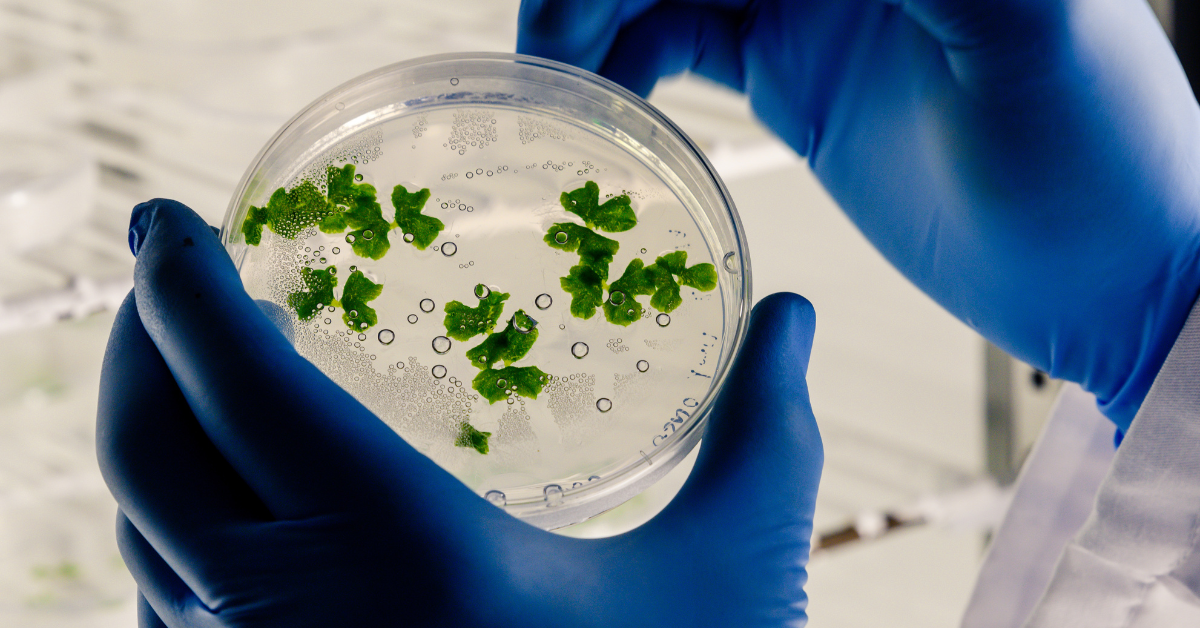

Industries we serve
At LabGuard, we are proud to be a leading provider of high-quality lab fume hoods, lab furniture, and comprehensive turnkey lab design and construction services. Our expertise spans across a wide array of industries, each presenting unique challenges and requirements for laboratory environments. We understand that each industry demands precision, safety, and efficiency in their lab setups, and we tailor our solutions to meet these exacting standards.
Whether it’s the stringent regulatory compliance in pharmaceuticals, the advanced research needs in biotechnology, or the robust safety features required in chemical and petroleum labs, LabGuard delivers customized, state-of-the-art laboratory solutions. We also provide comprehensive Annual Maintenance Contracts (AMC) to ensure that your labs continue to function at peak performance, safeguarding your investments and supporting your ongoing research and production activities.
Our dedication to innovation and quality means that we work closely with our clients to understand their specific requirements, ensuring that our lab solutions not only meet but exceed industry standards. From the initial consultation to the final installation and ongoing support, LabGuard is your trusted partner in building and maintaining world-class laboratories.

Pharmaceutical
Pharmaceutical labs ensure sterile, controlled environments for precise testing and research, vital for developing life-saving drugs.
Biotechnology
Biotechnology labs drive innovation with advanced technology and precise conditions for genetic and cellular research.

Chemical

Flavours & Fragrance

Food & Beverage
Food and beverage labs ensure product safety and quality through rigorous testing and compliance with health regulations.

Electronics
Electronics labs ensure contamination-free environments and precision for developing and testing electronic components.

Education
Educational labs are versatile spaces designed for safe, functional learning and research across multiple scientific disciplines.

Healthcare
Healthcare labs ensure precise diagnostics and treatment research with strict hygiene and safety standards.

Petroleum
Petroleum labs ensure durability and safety for testing and developing products under extreme conditions.
